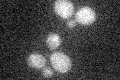
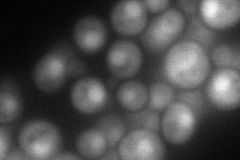
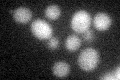
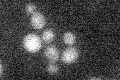

View description
Third-largest subunit of DNA polymerase II (DNA polymerase epsilon), required to maintain fidelity of chromosomal replication and also for inheritance of telomeric silencing; mRNA abundance peaks at the G1/S boundary of the cell cycle
Localization:
Intensity:
Fold change:
Significance:
-
C’ GFP library in SD
below threshold16.61 -
N' NOP1pr-GFP in SD

cytosol,nucleus134.565 -
N' TEF2pr-mCherry in SD
nucleus102.557 -
N' NATIVEpr-GFP in SD

nucleus36.8036 -
N' TEF2pr-VC and Cyto-VN in SD

nucleus37.5071 -
C’ GFP library in SD+DTT
cytosol13.540.81No -
C’ GFP library in SD+H2O2

cytosol16.440.98No -
C’ GFP library in Starvation Media
cytosol17.441.05No -
C’ GFP library on the background of Pup2-DaMP

below threshold -
C’ GFP library on the background of CCT mutant

below threshold17.21921.03644No
